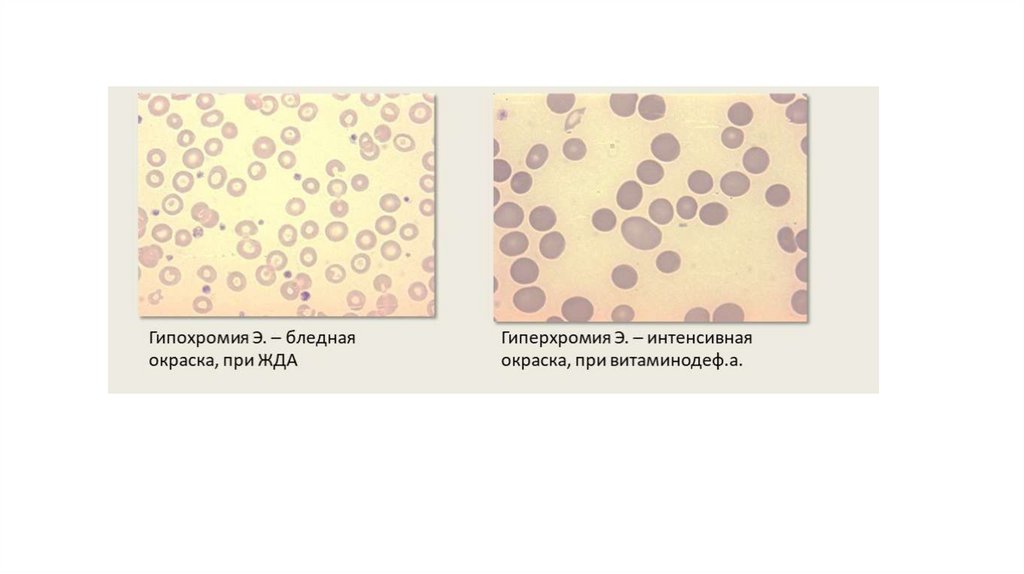

Similar presentations:
Физиология крови
1.
Физиология крови2.
Кровь, лимфа, тканевая и цереброспинальнаяжидкости составляют внутреннюю среду организма.
Из внутренней среды ткани получают все
необходимое для жизнедеятельности.
Из тканей во внутреннюю среду поступают продукты
жизнедеятельности, как подлежащие выведению из
организма, так и оказывающие определенное влияние
на процессы обмена.
3.
Система крови – это совокупность органов кроветворения, периферической крови, органовкроверазрушения и нейрогуморального аппарата регуляции.
4.
Объем крови составляет 6–8% массы тела, т.е. примерно 4,5–6 л увзрослого человека (нормоволемия). Повышение общего объема крови
называется гиперволемия, снижение – гиповолемия.
5.
6.
Средние значения концентрации электролитов и неэлектролитов в плазме крови человекаОсмотическое давление
280-296 мосмоль/кг воды
Осмотическое давление определяет водный
обмен между клетками и межклеточным
пространством.
Гипотония
внеклеточной
жидкости
приводит к клеточному отеку.
Гипертония – уменьшение объема клеток.
7.
• Дыхательная – связывание и перенос О2 и СО2;• Трофическая (питательная) – обеспечение клеток питательными веществами;
• Экскреторная (выделительная) – перенос лекарственных, избыточных веществ,
продуктов метаболизма к органам выделения;
• Осуществление креаторных связей – межклеточная передача информации;
• Регуляторная:
Терморегуляторная;
Участие в водно-солевом обмене;
Гуморальная регуляция;
Поддержание стабильности ряда констант – рН, осмотического и
онкотического давления и др.
• Защитная:
Формирование клеточного иммунитета;
Формирование гуморального иммунитета;
Защита организма от кровопотери – свертывание крови.
8.
Вязкость крови – 5 у. е. ( вязкость воды равна 1 у. е.); плазмы – 1,7-2,2 у.е. Вязкость крови обусловленаналичием белков и эритроцитов. Вязкость увеличивается при сгущении крови, т. е. в результате
потери воды, при возрастании количества эритроцитов.
Гематокритное число (ГЧ), гематокрит – количество форменных элементов крови, выраженное в
процентах от общего количества крови. На долю форменных элементов приходится 40–45%, на долю
плазмы – 55–60%; у мужчин – 44–46%, у женщин – 41–43%, у новорожденных – на 20% выше, чем у
женщин.
Гематокритом называют также часть объема крови, приходящуюся на долю эритроцитов, поскольку
они составляют наибольшее количество среди форменных элементов. Увеличение гематокрита
приводит к возрастанию вязкости крови и, соответственно, гидродинамического сопротивления,
поэтому любое патологическое увеличение гематокрита сопровождается повышением нагрузки
на сердце и сосуды, что приводит к нарушению кровообращения.
9.
Осмотическое давление плазмы крови составляет 7,3 атм. (5600 мм.; рт. ст. 285-296 мосмоль/кгН2О).Растворы, осмотическое давление которых такое же, как у плазмы, называют изотоническими, растворы с
большим осмотическим давлением – гипертоническими, с меньшим – гипотоническими.
Примерно 96% осмотического давления крови обусловлено наличием неорганических электролитов, в
основном Na+ и Cl-.
Эритроциты, в изотонических растворах сохраняют свой объем и свойства, в гипертонических происходит их
сморщивание – плазмолиз, а в гипотонических – увеличение объема в результате перехода воды внутрь
элементов, вплоть до разрыва эритроцита – это явление называется гемолиз (осмотический).
10.
Основные принципы регуляции осмотического давления, ионного состава и объема внеклеточнойжидкости (интерстициальной жидкости + внутрисосудистой воды).
Волюморегуляция, то есть регуляция объема внеклеточной воды, осуществляется с участием
волюморецепторов. Они реагируют на изменение объема жидкости и передают информацию по
афферентным волокнам к центру волюморегуляции (гипоталамуса). В регуляции объема внеклеточной
жидкости принимают участие также баро- и осморецепторы.
Осморегуляция – это поддержание на заданном уровне величины осмотического давления крови.
Осуществляется при участии осморецепторов, расположенных в супраоптических ядрах гипоталамуса,
печени, почек, сердца. В такой регуляции принимают участие соответственно барорецепторы и
волюморецепторы). На основе афферентации к центру осморегуляции (гипоталамус) происходит изменение
продукции антидиуретического гормона (АДГ), что приводит к изменению реабсорбции воды в почках.
Изменяется продукция ренина в почках, ангиотензина и альдостерона соответственно, что влияет на
реабсорбцию ионов Na+. Регуляция содержания воды и ионов Na+ происходит также с участием
натрийуретического гормона (атриопептида). Регуляция ионного состава крови тесно связана с волюмо- и
осморегуляцией, направлена на поддержание уровня отдельных ионов. Рецепторы, воспринимающие
уровень ионов – натриевые, калиевые, кальциевые, хлорные локализованы в печени, гипоталамусе.
Информация от рецепторов передается в соответствующий центр (гипоталамус). От гипоталамуса сигналы
управления направлены к железам внутренней секреции: коре надпочечников (альдостерон), поджелудочной
железе (инсулин). Кровь непосредственно влияет на почки, изменяя активность ренин-ангиотензинальдостеронового механизма, а также на другие железы, продуцирующие ионрегулирующие гормоны.
11.
12.
Белки кровиОбщее содержание всех белков крови составляет в норме
65-85 г/л. Белки плазмы крови разделяют на альбумины, глобулины, фибриноген.
13.
Функции белковСоздание коллоидно-осмотического давления
Ферментативно-метаболическая
Транспортная жиров, гормонов, металлов
Обеспечение буферных свойств
Нутритивная (пул аминокислот)
Гемостатическая
Иммунологическая
14.
Онкотическое давление плазмы кровиБелки, будучи осмотически активными частицами, как
правило, не способны выходить за пределы кровеносных
сосудов, поэтому они удерживают определенное количество
воды во внутрисосудистом пространстве.
Величина онкотического давления крови составляет в норме
25–30 мм.рт.ст.; 2 мосмоль/л.
Гипопротеинемия возникает при злокачественных
образованиях, после кровотечений, сильных ожогов и других
опасных для жизни состояний.
Гиперпротеинемия возникает и при заболеваниях, связанных с
большими потерями организмом воды. Так, при диарее,
несахарном мочеизнурении, неукротимой рвоте, ограничении
питья кровь сгущается и концентрация белка в ней возрастает.
15.
Сывороткой называют плазму крови, лишенную фибриногена.Ее химический состав почти идентичен составу плазмы, поэтому многие биохимические анализы крови
основаны на исследовании сыворотки. Сыворотку крови используют и в процессах иммунизации
человека.
Онкотическое давление плазмы крови обусловлено всеми белками крови, но основной вклад вносит
альбумин – до 75–80%.
Гипопротеинемия приводит к проявлению таких клинических последствий, как отек и шок.
Отек – это состояние, при котором происходит накопление внесосудистой жидкости. Накапливающиеся
в тканях вода и соли образуют «отечную» жидкость. Например, асцитная жидкость, которая
накапливается в брюшной
полости при поражениях печени, образуется в результате гипоальбуминемии и повышенного кровяного
давления в воротной вене.
Шок – это нарушение циркуляции, которое возникает при потере жидкости системой кровообращения.
У лиц, получивших сильные ожоги или травмы, капилляры становятся проницаемы для белков, поэтому
в межклеточное
пространство переходят большие объемы жидкости, что приводит к уменьшению объема крови в
сосудистом русле.
16.
Отдельные клинически важные белки плазмы крови:Гаптоглобин – белок, связывающий гемоглобин. Освобождается при разрушении эритроцитов, предотвращает
появление в плазме крови свободного гемоглобина при не слишком сильном внутрисосудистом гемолизе эритроцитов.
Трансферрин (сидерофилин) – один из компонентов β-глобулиновой фракции плазмы крови. Легко связывается с
железом, освобождающимся в тканях или всасывающимся из кишечника; играет роль переносчика железа.
Церулоплазмин – α2−глобулин, способный связывать медь. Обнаруживает свойства оксидазы аскорбиновой кислоты,
дигидроксифенилаланина (ДОФА) и адреналина.
С-реактивный белок. В плазме крови здоровых людей не обнаруживается. Однако этот белок всегда появляется и
может быть обнаружен на электрофореграммах при острой фазе ревматизма, инфаркте миокарда, острых заболеваниях,
вызванных пневмококками, стрептококками или стафилококками, а также других патологических состояниях, которые
сопровождаются некрозом или воспалительными процессами в тканях. Приобрел свое название вследствие
способности взаимодействовать in-vitro с С-полисахаридом пневмококков с образованием преципитата.
Пропердин. В норме содержится в сыворотке крови, составляет ~0,3% от общего количества белка. Входит в состав
гамма-глобулиновой фракции. Обладает бактерицидными свойствами, лизирует (разрушает) многие микробы, особенно
грамм-отрицательные бактерии, некоторые вирусы. Обнаружен некоторый параллелизм между активностью
пропердиновой системы крови и степенью резистентности организма к ряду инфекций. При лучевой болезни
содержание пропердина в плазме крови понижается, что является одной из причин снижения естественного
иммунитета при этом заболевании.
Интерферон. Специфический белок, появляющийся в клетках в результате проникновения в них вирусов. Угнетает
размножение вирусов, но не разрушает уже имеющиеся вирусные частицы. Легко проникает в кровеносное русло.
17.
Система кининов плазмы крови.В состав полипептидов плазмы крови входят кинины, из которых наибольшее значение имеют
брадикинин и каллидин.
Эти полипептиды образуют кининовую систему, играющую чрезвычайно важную роль в регуляции
местного и общего кровотока. Они влияют на проницаемость сосудистой стенки и ряд других клеточных
функций.
Брадикинин является наиболее сильным сосудорасширяющим веществом, что объясняется
расслабляющим действием кининов на гладкую мускулатуру сосудов.
Кининовая система играет определяющую роль и в патогенезе воспалительных процессов, ревматизма,
шока и других патологических состояний.
В крови брадикинин и каллидин находятся в неактивном состоянии в форме брадикининогена и
каллидиногена. Переход в активную форму происходит под действием особого фермента калликреина,
также содержащегося в плазме крови и в тканях в неактивной форме (калликреиноген).
18.
Скорость оседания эритроцитов (СОЭ).Удельная масса эритроцитов выше удельной массы плазмы, поэтому в пробирке с кровью, несвертывающейся при
добавлении антикоагулянтов (обычно цитрата натрия), происходит разделение на два слоя: верхний светлый
(плазму) и нижний темный (форменные элементы).
19.
20.
СОЭ в большей мере (за редким исключением) отражает степеньдиспротеинемии:
чем более выражена диспротеинемия, тем более ускорена СОЭ.
Иногда уже по одной резко ускоренной СОЭ (70-80 мм/час и более) можем
заподозрить диагноз миеломной болезни у пожилого пациента, зная, что
при этой болезни особенно выражена диспротеинемия за счет
гиперпродукции парапротеинов (аномальных и функционально
неполноценных белковых тел из группы иммуноглобулинов) костным
мозгом.
21.
Факторы, влияющие на оседание эритроцитов:1. Морфологические факторы
Важную роль в оседании эритроцитов играют их количество в единице объема крови, форма и диаметр, а
также количество гемоглобина в эритроцитах.
С ростом концентрации эритроцитов растет сопротивление движению и скорость их оседания в плазме
падает. При количестве эритроцитов более 5,5 *1012/л оценка СОЭ вообще невозможна.
В связи с этим при малых концентрациях (например, при анемиях) скорость оседания может быть
значительно повышена, в то время как агрегация выражена слабо.
На
показатели
СОЭ
также
оказывают
влияние
Число, форма и размер эритроцитов также влияют на оседание.
форма
и
размер
эритроцитов.
Эритроцитопения ускоряет оседание, а эритроцитоз его замедляет, однако при выраженной серповидности,
сфероцитозе, анизоцитозе скорость оседания эритроцитов может быть низкой, несмотря на анемию,
поскольку форма клеток препятствует образованию монетных столбиков.
В то же время увеличенные в объеме эритроциты (макроциты) оседают быстрее мелких (миафоцитов), это
хорошо прослеживается при выраженном анизоцитозе, когда верхняя граница эритроцитарного столба в
капилляре оказывается нечеткой из-за разной скорости оседания.
22.
2. Физико-химические факторы• рН плазмы: сдвиг в сторону ацидоза - снижает, в сторону алкалоза - повышает СОЭ;
• ионный заряд плазмы: его снижение ускоряет оседание;
• содержание желчных кислот и желчных пигментов: увеличение их количества ведет к уменьшению
СОЭ;
• липиды крови: при увеличении содержания холестерина СОЭ увеличивается;
• вязкость крови: при ее увеличении СОЭ уменьшается;
• наличие антиэритроцитарных антител: изо- и аутоагглютинины, изменяя специфически
эритроцитарную поверхность, способствуют их склеиванию и ускоряют оседание.
23.
Ускоряющие СОЭ факторы способствуют быстрому склеиванию эритроцитов в крупные агломераты. Кподобным факторам относятся субстанции, накапливающиеся в крови при инфекционных
воспалительных процессах, опухолевом росте, некрозе тканей. Такими веществами являются:
фибриноген, глобулин, гаптоглобин, церулоплазмин, гиалуроновая кислота, хондроитинсерная кислота,
парапротеины, циркулирующие иммунные комплексы, декстраны, жировые эмульсии, пероральный
прием контрацептивов, бисептола, кортизона. К факторам, ускоряющим СОЭ, относятся также
беременность и анемии.
К числу факторов, препятствующих агломерации эритроцитов и, следовательно, снижающие СОЭ
относят: увеличение количества эритроцитов в единице объема крови, уменьшение диаметра
эритроцитов (микроцитоз) и их формы (серповидность), повышение вязкости крови, снижение
температуры в рабочей комнате, сдвиг рН в кислую сторону, нарастание в крови содержания
билирубина, желчных кислот, холестерина, при приеме лекарственных препаратов (диуретиков,
салицилатов, глюкозы, хинина).
24.
pH крови:Изменение pH крови может влиять на заряд поверхности эритроцитов и их способность к агрегации.
При снижении pH (ацидоз), когда кровь становится более кислой, эритроциты могут становиться менее
отрицательно заряженными, что способствует их склеиванию и увеличению СОЭ.
При повышении pH (алкалоз), наоборот, отрицательный заряд эритроцитов увеличивается, что затрудняет
их агрегацию и уменьшает СОЭ.
Концентрация белков плазмы: Белки плазмы, такие как фибриноген и глобулины, играют важную роль в
процессе агглютинации эритроцитов. Их концентрация также зависит от КОС.
В условиях ацидоза концентрация этих белков может увеличиваться, способствуя агрегации эритроцитов и
повышению СОЭ.
Алкалоз, напротив, может снижать концентрацию таких белков, уменьшая склонность эритроцитов к
агрегации и снижению СОЭ.
Воспалительные процессы: Кислотно-основной дисбаланс часто сопровождает воспалительные состояния,
при которых повышается уровень воспалительных маркеров, таких как С-реактивный белок и интерлейкины.
Эти вещества способствуют агрегации эритроцитов и увеличивают СОЭ.
Таким образом, изменения в кислотно-основном состоянии крови могут существенно влиять на скорость
оседания эритроцитов через изменение заряда клеток, концентрации белков плазмы и наличие воспалительных
процессов.
25.
Ацидоз, то есть снижение рН крови ниже нормы (менее 7,35), действительно может снизить скоростьоседания эритроцитов (СОЭ). Вот основные причины этого явления:
Изменение заряда эритроцитов: В нормальных условиях эритроциты имеют отрицательный заряд
на своей поверхности, который препятствует их агрегации (склеиванию). Ацидоз приводит к
снижению рН крови, что уменьшает отрицательный заряд эритроцитов. Это делает их менее
отталкивающимися друг от друга и способствует агрегации.
Увеличение вязкости крови: При ацидозе происходит сгущение крови за счет увеличения
концентрации некоторых белков, таких как фибриноген и иммуноглобулины. Это увеличивает
вязкость крови и замедляет движение эритроцитов, что ведет к снижению СОЭ.
Гемолиз эритроцитов: В условиях сильного ацидоза может происходить разрушение (гемолиз)
части эритроцитов. Гемолизированные эритроциты теряют свою форму и способность оседать, что
также снижает общую скорость оседания эритроцитов.
Гипоксия: Ацидоз часто связан с гипоксией (недостатком кислорода), так как оба эти состояния
могут возникать одновременно, например, при дыхательной недостаточности. Гипоксия вызывает
компенсаторную реакцию организма, направленную на улучшение доставки кислорода к тканям, что
включает в себя увеличение количества эритроцитов и изменение их формы, что может повлиять на
СОЭ.
Влияние на белки плазмы: Некоторые белки плазмы, участвующие в агрегации эритроцитов,
могут изменять свои свойства под воздействием ацидоза. Например, уменьшение активности
альбумина может привести к снижению его способности связывать воду, что изменяет осмотическое
давление и влияет на СОЭ.
26.
Кислотно-основное состояние крови (КОС).Это один из важнейших и наиболее стабильных параметров постоянства внутренней среды. От
соотношения концентраций водородных и гидроксильных ионов во внутренней среде организма зависят
активность ферментов, интенсивность и направленность окислительно-восстановительных реакций,
процессы обмена белков, углеводов и липидов, функции различных органов и систем.
Активность реакции среды влияет на способность гемоглобина связывать кислород и отдавать его
тканям. Активную
реакцию среды оценивают показателем рН, который отражает содержание в жидкостях ионов водорода.
Кислотно-основное состояние (КОС) поддерживается буферными системами крови, а
регулируется с помощью легких, желудочно-кишечного тракта, почек.
27.
28.
Эритроцитоз — состояние, характеризующееся увеличением количества эритроцитов в периферическойкрови. В соответствии с механизмами развития этого состояния различают относительный и абсолютный
эритроцитоз. Относительный эритроцитоз возникает в том случае, когда увеличивается количество
эритроцитов в единице объема крови в связи со сгущением крови, но эритропоэз не активируется.
Относительный эритроцитоз может иметь место при физической нагрузке, а также ожогах, когда возникает
выраженная плазмопотеря через тканевую поверхность, при неукротимой рвоте в случае кишечной
непроходимости, токсикозе беременности, при диареях, сопровождающих холеру, дизентерию и другие
кишечные инфекции.
Абсолютный эритроцитоз — состояние, характеризующееся увеличением количества эритроцитов в
периферической крови вследствие усиления эритропоэза.
Абсолютный эритроцитоз бывает двух видов:
1. Компенсаторный – обеспечивает развитие компенсаторноприспособительных реакций в условиях
патологии, например, при сердечной недостаточности или у здоровых лиц – жителей высокогорных районов,
в связи с хронической гипоксией и стимуляцией эритропоэза.
2. Патологический – не обеспечивает адаптационных реакций; имеет место при опухолевом поражении
почек, надпочечников, гипофиза, что сопровождается усилением продукции гуморальных и гормональных
стимуляторов эритропоэза.
Эритропения – это состояние, характеризующееся снижением в крови количества эритроцитов. В
соответствии с механизмами развития эритропении могут носить абсолютный или относительный характер.
Относительная эритропения обусловлена увеличением поступления жидкости в организм, разжижением
крови, что приводит к уменьшению количества эритроцитов в единице объема крови при сохраненном
эритропоэзе. Абсолютная эритропения связана с различными патогенетическими факторами:
подавлением эритропоэза, усилением разрушения эритроцитов или усиленной кровопотерей, что приводит к
уменьшению содержания эритроцитов в периферической крови.
29.
Помимо зрелых эритроцитов, в периферической кровициркулируют ретикулоциты, число которых в норме
составляет 1-2%.
Это молодые безъядерные клетки, они образуются на
последнем
этапе
созревания,
предшествующем
образованию эритроцита.
Количество ретикулоцитов в периферической крови
позволяет судить об интенсивности эритропоэза,
компенсаторно-приспособительных реакциях в условиях
нормы и патологии.
При усилении эритропоэза возникает ретикулоцитоз –
увеличение количества ретикулоцитов в крови.
30.
Физико-химические свойства эритроцитовПластичность – способность к обратимой деформации при движении через
микропоры и узкие капилляры диаметром до 2,5–3 мкм. Пластичность
определяется особенностями цитоскелета. По мере старения способность
эритроцитов к деформации снижается, они превращаются в сфероциты и не могут
проходить через узкие капилляры. Поэтому они задерживаются красной пульпой
селезенки, а затем фагоцитируются клетками мононуклеарной фагоцитирующей
системы.
Осмотические свойства
Осмотическое давление в эритроцитах несколько выше, чем в плазме крови, что
обеспечивает тургор клеток. Это обусловлено более высокой внутриклеточной
концентрацией белков по сравнению с плазмой крови, хотя содержание
низкомолекулярных веществ ниже.
При помещении эритроцитов в гипотоническую среду происходит осмотический
гемолиз, что обусловлено поступлением воды до того момента, когда мембрана
эритроцитов разрушается и гемоглобин выходит в окружающую среду.
В умеренно гипотонической среде эритроциты приобретают сферическую форму.
31.
Осмотическая резистентность, т. е. устойчивостьэритроцитов к гипотоническим растворам,
характеризуется
таким
диапазоном:
максимальная степень гемолиза возможна при
концентрации
0,28
%
раствора
NaCl,
минимальная –при 0,48 % раствора NaCl.
Пониженная осмотическую стойкость эритроцитов характерна для пациентов с наследственным
сфероцитозом.
Сфероциты являются осмотически менее стойкими клетками, которые легче
лизируются в гипотоническом растворе, по сравнению с нормальными эритроцитами.
Повышенная осмотическая стойкость эритроцитов указывает на наличие сплющенных эритроцитов
(лептоцитов), у которых снижено соотношение площади поверхности к объему. Такое изменение
происходит при железодефицитной анемии, талассемии и серповидноклеточной анемии, так как
эритроциты с низким содержанием гемоглобина (MCH) и низким средним объемом клеток (MCV)
необычайно устойчивы к осмотическому лизису. Ретикулоциты и эритроциты у пациентов после
спленэктомии также более осмотически устойчивые по сравнению с нормальными клетками. При
заболеваниях печени вследствие пассивного накопления липидов эритроциты также более устойчивы к
осмотическому лизису.
32.
Виды гемолиза эритроцитов.Гемолиз – это разрушение оболочки
эритроцитов, которое сопровождается выходом
гемоглобина в плазму крови.
В зависимости от действия факторов,
повреждающих эритроциты,
различают следующие виды гемолиза:
– коллоидно-осмотический;
– химический – происходит под влиянием
веществ, разрушающих оболочку эритроцитов;
– механический – при сильных механических
воздействиях;
– термический – при замораживании или
размораживании крови;
– биологический – при переливании
несовместимой крови, укусах некоторых змей,
действии иммунных гемолизинов.
33.
Агрегация эритроцитовПри замедлении движения крови и повышении ее вязкости эритроциты образуют
агрегаты, обусловливая изменение реологических проявлений крови. Так
происходит при разных критических и терминальных состояниях, например,
травматическом шоке, постинфарктном коллапсе, перитоните. Вначале агрегация
носит обратимый характер, образуются ложные агрегаты или «монетные
столбики».
При длительном нарушении кровотока образуются истинные агрегаты. На этой
стадии возникает микротромбообразование, нарушается микроциркуляция.
34.
Цветовой показатель крови (ЦП). Этот показатель выражает соотношение между количеством гемоглобина ичислом эритроцитов крови, т. е. показывает степень насыщения эритроцитов гемоглобином.
Для расчета ЦП определяют количество эритроцитов в 1л крови и содержание гемоглобина в г/л. В норме ЦП у
детей и взрослых колеблется в пределах 0, 85-1,1 (нормохромия).
ЦП применяется для дифференциальной диагностики гипо-, нормо- и гиперхромных анемий.
Если ЦП в норме и на этом фоне отмечается сниженное количество эритроцитов – говорят о нормохромии,
характерной для острого или хронического кровотечения, почечной патологии, приводящей к нехватке
эритропоэтина, внутрисосудистого гемолиза и апластических состояний.
Уменьшение ЦП свидетельствует о гипохромной анемии, что бывает при:
•Дефиците железа и витамина В6;
•Отравлении тяжелыми металлами;
•Нарушении синтеза белков и других соединений, входящих в состав гемоглобина (талассемия);
•Общем тяжелом состоянии пациента.
Гиперхромия, когда ЦП выше нормы, свидетельствует о:
•Недостаточности в организме витамина В12 и фолиевой кислоты;
•Токсическом поражении костного мозга;
•Передозировке или длительном лечении цитостатиками, противосудорожными, противовирусными препаратами;
•Гипотиреозе;
•Нарушении работы печени.
35.
36.
Кислородная емкость кровиМаксимальное количество кислорода,
которое может связать кровь при полном
насыщении гемоглобина кислородом,
называется кислородной емкостью
крови (КЕК).
1 моль гемоглобина может связать до 4
моль О2, соответственно
1г Нb in vivo связывает 1, 34 мл О2 (число
Хюфнера).
Зная содержание гемоглобина в крови,
можно вычислить КЕК: (1, 34 мл О2 на 1 г
Нb) * (150 г Нb на 1 л крови) = 0,2 л. О 2 на
1 л крови.
37.
Эритропоэз – это процесс образования эритроцитов в организме.Он происходит в миелоидной ткани – эпифизах трубчатых и полости губчатых костей,
красном костном мозге.
Поддержание постоянного количества эритроцитов в периферической крови, имеющих
продолжительность жизни около 120 дней, возможно при определенной интенсивности
эритропоэза.
Ежесуточно в костном мозге человека массой 70 кг образуется 20-25х1010 эритроцитов,
а из костного мозга в кровь освобождается за 1 мин. 1.8х109 молодых эритроцитов –
ретикулоцитов.
Через 20 – 40 ч после выхода из костного мозга ретикулоциты превращаются в зрелые
эритроциты – нормоциты.
38.
Важнейшим регулятором эритропоэза является эритропоэтин.По физико-химическим свойствам он относится к группе кислых гликопротеидов. Главным образом синтезируется в
почках, в небольших количествах образуется и в других органах – в основном, в печени. Продукция эритропоэтина в
почках существенно возрастает при гипоксии любого происхождения (сердечная и легочная недостаточность,
кровопотеря, гемолиз эритроцитов, снижение барометрического давления). Эритропоэтин, который достигает клеток
красного костного мозга, взаимодействует с рецепторами клеток.
Выполняет следующие действия:
– ускорение и усиление перехода стволовых клеток в эритробласты;
– увеличение числа митозов клеток эритроидного ряда;
– ускорение созревания неделящихся клеток – нормобластов, ретикулоцитов;
– продление срока жизни незрелых предшественников клеток эритроидного ряда.
Важнейшими модуляторами эритропоэза являются гормоны.
Тропные гормоны аденогипофиза (АКТГ, ТТГ, ГТГ) оказывают стимулирующее воздействие на эритропоэз благодаря
усилению продукции соответствующих гормонов периферическими эндокринными железами – глюкокортикоидов.
Тиреоидные гормоны оказывают стимулирующее воздействие не только путем повышения почечной продукции
эритропоэтина, но и путем прямого действия на эритропоэтиновые клетки.
В отличие от андрогенов эстрогены оказывают тормозящее действие на эритропоэз.
Установлено, что инсулин в больших концентрациях стимулирует образование эритропоэтина; а глюкагон оказывает
ингибирующие влияние на эритропоэз.
39.
Регуляторами эритропоэза являются также микроэлементы (железо, медь,марганец, цинк) и витамины. Микроэлементы необходимы для
следующего:
а) созревания эритробластов, дифференцировки их в нормоциты;
б) синтеза гема и глобина;
в) стимуляции образования эритропоэтинов;
г) повышения обмена веществ в кроветворных органах, усиления
насыщения эритроцитов гемоглобином.
Следствием недостатка железа, например, в пище, или при нарушении
всасывания его в пищеварительном тракте, хронической кровопотере
является возникновение железодефицитной анемии. При этом заболевании
в крови находятся мелкие эритроциты с пониженным содержанием
гемоглобина (гипохромная микроцитарная анемия).
40.
В регуляции эритропоэза большую роль играют фолиевая кислота и витамин В12.Суточная потребность человека в фолиевой кислоте составляет 1-2 мг. Фолиевая кислота стимулирует
процессы биосинтеза ДНК в клетках костного мозга.
Витамин В12 (кобаломин) представляет собой внешний фактор кроветворения (Кастла) и поступает в
организм с пищей. Суточная потребность в этом витамине составляет 0,003 мг для взрослого человека.
Его усвоение возможно только при наличии внутреннего фактора Касла – гастромукопротеида, который
вырабатывается париетальными клетками слизистой оболочки желудка. При взаимодействии внешнего
и внутреннего факторов образуется комплекс, в котором витамин В12 защищен от утилизации его
микрофлорой кишечника. Эти вещества способствуют созреванию эритроцитов. Дефицит таких веществ
приводит к замедлению деления клеток, но скорость роста при этом не изменяется, поэтому образуются
патологически увеличенные клетки.
Анемия (мегалобластическая) при недостатке В12 или фолиевой кислоты возникает в результате
уменьшения продолжительности жизни мегалоцитов, медленного созревания эритроцитов.
Для эритропоэза также необходимы:
– витамин С – участвует во всех этапах обмена железа;
– витамин В6 (пиридоксин) – влияет на ранние фазы синтеза гема;
– витамин В12 (рибофлавин) – для образования липидной стромы эритроцитов;
– пантотеновая кислота – для синтеза фосфолипидов.
41.
Разрушение эритроцитов. Продолжительность жизни эритроцитов в кровяном руслесоставляет около 120 дней. По истечении этого срока они разрушаются в
ретикулоэндотелиальной системе, главным образом в селезенке. Ежедневно разрушается около
1% эритроцитов и такое же количество образуется в красном костном мозге. Число эритроцитов в
периферической крови пополняется за счет зрелых эритроцитов и частично ретикулоцитов.
Аминокислоты из цепей глобина возвращаются в метаболизм, а железо извлекается
из гема для повторного использования в синтезе гемоглобина.
Остатки гемовой структуры разлагаются до билирубина, конъюгируют с
глюкуроновой кислотой и выводятся с желчью.
В тонкой кишке билирубин превращается в стеркобилин; большая часть
стеркобилина выводится из организма, но небольшое количество реабсорбируется и
выводится почками в виде уробилиногена.
Усиленное разрушение эритроцитов из-за гемолиза или неэффективного гемопоэза
приводит к развитию желтухи и увеличению содержания уробилиногена в моче.
Свободный внутрисосудистый гемоглобин токсичен и обычно связан с
гаптоглобинами — белками плазмы крови, образующимися в печени.
42.
43.
Лейкоциты, или белые кровяные тельца –это клетки с ядрами.
Образуются к красном костном мозге
(гранулоциты, моноциты), лимфатических узлах,
селезенке,
вилочковой
железе
(лимфоциты).
Продолжительность жизни 15-20 дней.
Основные функции лейкоцитов:
• защитная – фагоцитоз микробов, бактерицидное и антитоксическое действие, участие
в иммунных реакциях, в процессе свертывания крови и фибринолиза;
• регенеративная – заживление поврежденных тканей;
• транспортная – лейкоциты являются носителями ряда ферментов.
44.
Все виды лейкоцитов способны к амебовидному движению, благодарячему они могут мигрировать через стенку кровеносных сосудов –этот
процесс называется диапедез.
Они обладают положительным хемотаксисом по отношению к
бактериальным токсинам, продуктам распада бактерий или клеток
организма и комплексам антиген–антитело.
45.
Лейкоцитыделятся
на
2
группы:
гранулоциты
(зернистые)
и
агранулоциты (незернистые).
46.
Нейтрофилы представляют собой наиболее многочисленные лейкоциты крови и являются «первой линией» защитыот патогенов в очаге воспаления, где осуществляют такие эффекторные функции, как фагоцитоз, дегрануляция,
генерация активных форм кислорода и образование нейтрофильных внеклеточных ловушек.
47.
Базофилы синтезируются в костном мозге, оттудапопадают в сосудистое русло, а затем мигрируют в ткани.
Такие тканевые базофилы называются тучные клетки.
Срок жизни базофилов — примерно 7 дней.
В норме содержание базофилов очень низкое — 0–1% от
общего количества лейкоцитов.
Если в организме возникает аллергическое воспаление, то базофилы вместе с эозинофилами мигрируют
в воспалительный очаг, и высвобождают из своих гранул — гистамин, серотонин и гепарин.
Гистамин и серотонин способствуют расширению кровеносных сосудов. Благодаря этим веществам больше клеток
иммунной системы могут добраться до очага воспаления. А гепарин замедляет свёртывание крови — таким
образом снижается риск формирования тромбов.
Также гранулы базофилов содержат простагландины — вместе с гистамином они связывают и нейтрализуют
аллергены.
48.
Эозинофилыучаствуют
в
патогенезе
аллергических заболеваний и паразитарных
инвазий, играют существенную роль в механизмах
формирования
бактериальных
и
вирусных
инфекций, в противоопухолевом иммунитете.
Эозинофилы играют решающую роль в аллергических
реакциях. Присутствующая в малых гранулах эозинофилов
гистаминаза
осуществляет
регуляцию
содержания
гистамина
путем
его
инактивации.
Эозинофилы
презентируют на своей поверхности многочисленные
рецепторы способные, связывать небелковые антигены
бактерий, что позволяет рассматривать эозинофилы в
качестве антиген распознающих клеток, реализующих свои
потенции на первом этапе иммунной защиты.
Эозинофил
является
одной
из
наиболее
агрессивных эффекторных клеток воспаления,
обладающих
высоким
цитотоксическим
потенциалом.
При столкновении с паразитами эозинофилы
высвобождают
содержимое своих гранул
(токсичные белки, эозинофильную пероксидазу и
эозинофильный катионный белок), которое
напрямую повреждает кутикулу паразита или
воспаленные ткани.
После активации эозинофилы могут высвобождать
ряд цитокинов, хемокинов и факторов роста,
которые поддерживают воспалительную реакцию.
49.
Лимфоциты - это клетки иммунной системы, представляющие собой разновидность лейкоцитов, которыеобеспечивают гуморальный иммунитет (выработка антител), клеточный иммунитет (контактное
взаимодействие с клетками-мишенями), а также регулируют деятельность клеток других типов. По
морфологическим признакам выделяют два типа лимфоцитов: большие гранулярные лимфоциты (чаще всего
ими являются NK- клетки и малые лимфоциты (Т-клетки и В- клетки).
50.
1.Макрофаг (моноцит) путем фагоцитоза захватывает микроб (1).2. Ферменты лизосом начинают разлагать микроб. Антигенные фрагменты (специфический маркер микроба) (желтые
треугольнички) остаются внутри.
3.Фагоцит изготавливает белковый маркер (зеленая вилочка), антигенные фрагменты микроба (желтые треугольнички)
связываются с белковым маркером (зеленая вилочка) (2) и экспонируются на поверхность плазматической
мембраны (3).
4.Макрофаг становится антиген-презентирующей клеткой (АПК), которая секретирует медиатор воспаления и
активирует хелперные Т-клетки для продукции и секреции интерлейкина—2.
5.Интерлейкин-2 вызывает размножение цитотоксических Т-клеток (7) и В-клеток (6), которые далее участвуют в
иммунном ответе на инфекцию. Размножение самих Т-хелперов также поддерживается интерлейкином-2 (5).
51.
Количество лейкоцитов в крови здорового взрослого человека составляет от 4х109 до 9х109/литр крови.
Лейкоцитарная формула — процентное соотношение различных видов (форм)
лейкоцитов в крови, определяемое в мазке окрашенной крови.
52.
По механизмам развития выделяют два видалейкоцитоза:
- физиологический;
- реактивный.
53.
Физиологический лейкоцитоз является следствием выходалейкоцитов из депо (красный костный мозг, лимфоидная ткань), т.е.
является перераспределительным.
В крови лейкоциты находятся транзитом с целью доставки в ткани,
где высока вероятность попадания антигена. Основными причинами
физиологического лейкоцитоза являются:
- прием пищи;
- физическая нагрузка;
- эмоциональные переживания;
- действие болевого раздражителя;
- беременность.
54.
Реактивный лейкоцитоз является следствием стимуляции лейкопоэза.Усиление лейкопоэза приводит к увеличению общего содержания в крови лейкоцитов, в том числе незрелых
форм лейкоцитов.
Легче всего оценить нейтрофилопоэз (образование нейтрофилов), так как в процессе созревания в нейтрофилах
происходят выраженные морфологические изменения ядра.
В периферической крови выделяют зрелые формы нейтрофилов: сегментоядерные, и незрелые формы
нейтрофилов: миелоциты, юные (метамиелоциты) и палочкоядерные.
Соотношение незрелых форм нейтрофилов к зрелым формам нейтрофилов получило название ядерного
индекса (ЯИ) или индекса регенерации.
К незрелым формам нейтрофилов относятся юные (метамиелоциты) и палочкоядерные. К зрелым формам
нейтрофилов относятся сегментоядерные. Ядерный индекс рассчитывается по формуле:
ЯИ = (%миелоцитов + %метамиелоцитов + %палочкоядерных)/ %сегментоядерных
В норме величина ядерного индекса колеблется от 0,05 до 0,1.
Если ядерный индекс более 0,1 – сдвиг лейкоцитарной формулы влево, свидетельствующий об усилении
нейтрофилопоэза в красном костном мозге.
Таким образом, сдвиг лейкоцитарной формулы влево свидетельствует о реактивном лейкоцитозе.
Если ядерный индекс менее 0,05 - сдвиг лейкоцитарной формулы вправо, свидетельствующий об угнетении
нейтрофилопоэза в красном костном мозге.
55.
При оценке изменений количества лейкоцитов в клинике большое значениеимеют изменения соотношений разных видов лейкоцитов.
Сдвиг лейкоцитарной формулы влево — увеличение количества незрелых (палочкоядерных) нейтрофилов в
периферической крови, появление метамиелоцитов (юных), миелоцитов;
Сдвиг лейкоцитарной формулы вправо — уменьшение нормального количества палочкоядерных нейтрофилов
и увеличение числа сегментоядерных нейтрофилов с гиперсегментированными ядрами (мегалобластная
анемия, болезни почек и печени, состояние после переливания крови).
56.
Что значит сдвиг лейкоцитарной формулы влево и вправо?Нейтрофилы формируют антибактериальную и противогрибковую защиту организма, и когда
определенный микроб попадает в организм, количество нейтрофилов увеличивается. В этом случае
изменяется не только их общее количество, но и количество отдельных форм этих клеток.
Цепочка нейтрофилов, расположенных по созреванию:
Юные — палочкоядерные — сегментоядерные.
Сдвиг формулы влево — это увеличение количества молодых клеток, а сдвиг вправо — это
увеличение количества старых клеток.
Причины сдвига лейкоцитарной формулы
В медицинской практике чаще случается сдвиг влево. На это влияет наличие в организме острой
бактериальной или грибковой инфекции. Костный мозг мобилизуется для защиты организма и
начинает интенсивно вырабатывать нейтрофилы. Они начинают борьбу с инфекцией и погибают в
процессе. На смену зрелым клеткам вырабатываются молодые. В определенный момент количество
молодых клеток превышает число зрелых.
Повышение сегментоядерных нейтрофилов приводит к смещению лейкоцитарной формулы
вправо. Это происходит не только на фоне увеличения, но еще чаще при уменьшении количества
лейкоцитов. Этому способствуют длительные хронические инфекции, при которых запасы костного
мозга истощаются и молодые формы клеток перестают формироваться. Отравление, облучение,
химиотерапия и лучевая терапия, при которых также подавляется костный мозг, могут привести к
правильному сдвигу.
57.
Изосерологические системы крови человекаГрупповая система АВО стала первой открытой (К. Ландштейнер, 1901) изосерологической
системой крови.
Мембрана эритроцитов содержит специфические гликолипиды, обладающие антигенными свойствами.
Поэтому при переливании несовместимой крови происходит агглютинация эритроцитов в результате
реакции антиген–антитело.
Это может приводить к закупорке капилляров глыбками эритроцитов, повреждению почечных канальцев
в результате осуществления гемолиза эритроцитов и прочим гемотрансфузионным осложнениям.
Групповые антигены – это наследственные, врожденные свойства крови, не изменяющиеся в течение
жизни.
Каждая групповая система выделена по наличию двух или большего количества антигенов,
контролируемых аллельными генами.
Групповые антитела – непостоянное свойство крови.
Лишь в групповой системе АВО антитела не претерпевают существенных изменений в течение жизни.
Однако и эти антитела слабо или совсем не выражены при рождении и развиваются постепенно на
протяжении первого года жизни.
58.
59.
Структура мембраны эритроцитов в норме. Гибкость эритроцитарной мембраны обеспечивается благодаряприкреплению белков цитоскелета. Важные трансмембранные белки включают белок полосы 3 (ионный
транспортный канал) и гликофорин С (участвует в прикреплении цитоскелета и газообмене, а также является
рецептором для Plasmodium falciparum при малярии).
60.
61.
62.
63.
64.
Антигены системы резус встречаются со следующей частотой:Д – 85 %; С – 70 %; с – 80 %; Е – 30 %; е – 97,5%.
Антигены системы резус обладают способностью вызывать образование
иммунных антител.
Наиболее активным в этом отношении является антиген Д, который и
подразумевается под термином «резус – фактор».
Именно по наличию или отсутствию антигена Д все люди делятся на резус –
положительных и резус – отрицательных.
Иммуногенность других антигенов системы резус существенно ниже и
убывает в следующем ряду: с > Е > C > е. Обладая выраженными
иммуногенными свойствами, антиген D в 95 % случаев является причиной
гемолитической болезни новорожденных при несовместимости матери и
плода, а также частой причиной посттрансфузионных осложнений.
Доноры, на эритроцитах которых отсутствует антиген Д, но присутствует
один из антигенов С или Е, считаются резус – положительными.
65.
66.
67.
68.
Первичным ответом иммунной системы матери на попадание в кровоток резус-антигенов являетсявыработка IgM-антител, которые не проникают через плацентарный барьер к плоду из-за большой
молекулярной массы. Первичный иммунный ответ после попадания D-антигена в кровоток матери
проявляется через определенное время, которое составляет от 6 нед до 12 мес. Именно поэтому
большинство резус-отрицательных женщин, как правило, благополучно вынашивают свою первую
беременность.
При повторном попадании резус-антигенов в сенсибилизированный организм матери происходит
быстрая и массивная продукция IgG, которые вследствие низкой молекулярной массы способны
проникать через плацентарный барьер.
В половине случаев для развития первичного иммунного ответа достаточно попадания 50–75 мл
эритроцитов, а для вторичного — 0,1 мл.
Проходя через плацентарный барьер, резус-антитела разрушают эритроциты плода, вызывая
гемолитическую анемию и образование в большом количестве непрямого билирубина, что
вызывает желтуху. В результате возникает компенсаторное экстрамедуллярное кроветворение,
очаги которого локализуются преимущественно в печени плода и неизбежно приводят к
нарушению её функций. Развиваются портальная гипертензия, гипопротеинемия, водянка плода,
т.е. комплекс нарушений, называемый эритробластозом плода.
Это состояние требует лечения плода внутриутробно, либо родоразрешения и лечения
новорожденного, если срок беременности и возможности неонатальной службы позволяют
подобное лечение провести.
69.
70.
ИммуноглобулинПрепарат представляет собой иммунологически активную
белковую фракцию, выделенную из человеческой плазмы или
сыворотки доноров. Активным компонентом препарата является
иммуноглобулин G , содержащий неполные aнти-Rh(D)-aнтитeлa.
Препарат предотвращает резус-сенсибилизацию (образование
анти-Rh(D)-антител) при беременности у резус-отрицательных
женщин, родивших Rh(D)-положительных детей или перенесших
искусственное прерывание беременности при Rh(D)положительной принадлежности крови отца ребёнка.

medicine
medicine








